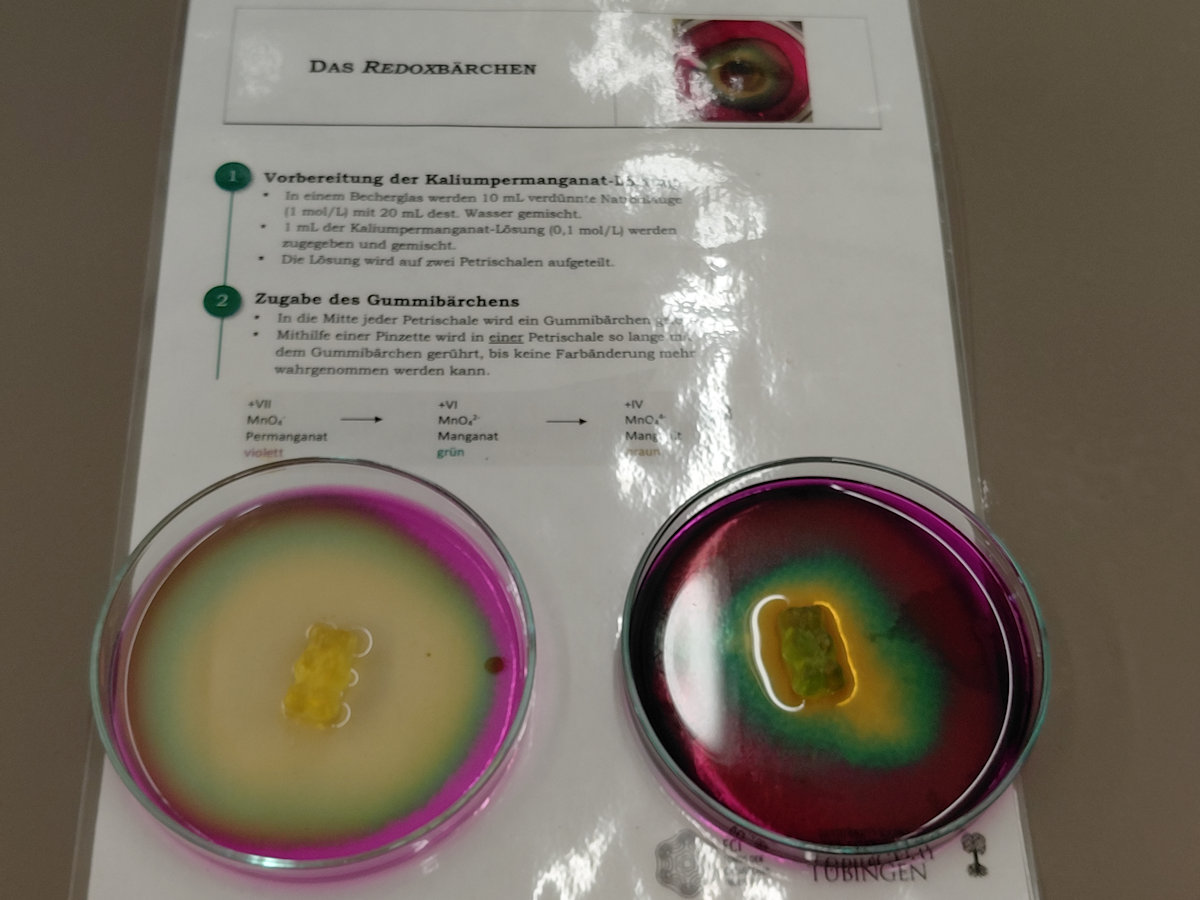

Ich mag keine Chemie… aber so gefällts mir!
Motivierende und einfache Experimente für den Chemieunterricht der Sek. I und II
Lehrkräftefortbildung am Samstag, den 22. November 2025, 9:30 - 16:00 Uhr, im Institut Dr. Flad
Referenten: Dr. Dominik Diekemper, Prof. Dr. Stefan Schwarzer
Chemiedidaktik der Universität Tübingen
Zielgruppe: Lehrkräfte aller Schularten - Hauptschulen, Realschulen, Gemeinschaftsschulen und Gymnasien
"Chemie – das habe ich (in der Schule) wirklich nie gemocht!"
Diese Aussage über den Chemieunterricht ist Lehrkräften des Fachs sicherlich bekannt. Sei es im Alltag oder eben in der Schule selbst. Das Image des Unterrichtsfachs ist seit Jahren negativ konnotiert, es gilt als starr, abstrakt und schwer verständlich. Dass Chemie einen Beitrag leistet, unser Leben nachhaltiger und einfacher zu gestalten, wird dabei oft übersehen.
Ein Alleinstellungsmerkmal naturwissenschaftlicher Fächer wie Chemie ist aber das Experimentieren im Unterricht. Aus diesem Grund ist das Ziel dieser Lehrkräftefortbildung das selbstständige Erproben von einfachen, aktuellen motivierenden und eindrucksvollen Experimenten für den Chemieunterricht aller Schularten zu den bildungsplanrelevanten Themenbereichen Energie und Licht, Redoxreaktionen, Pyrotechnik, Elektro- und Nanochemie.
Kostenlose Materialien für den Einsatz der vorgestellten Experimente in der Schule werden für Sie zur Mitnahme in Form von Materialboxen bereitgestellt.
Nach einem Impulsvortrag zu den Inhalten der Experimente und aktuellen experimentbezogenen Kontexten folgen im gemeinsamen Praktikum Experimente zu:
- Energie und Licht: Von leuchtendem Bubble-Tea und magischem Waschpulver.
- Redoxreaktionen: Elektronenübergänge mit Gummibärchen und Tomatensaft.
- Pyrotechnik: Herstellung von „grünen“ Wunderkerzen.
- Anfangsunterricht: Durchführungsvarianten der Flammenfärbung.
- Elektrochemie: Batterien in Teelichten und Zipperbeuteln.
- Nanochemie: Seifenblasen und superhydrophobe Oberflächen.
- Anfangsunterricht: Aggregatzustände mit selbst hergestelltem Trockeneis.